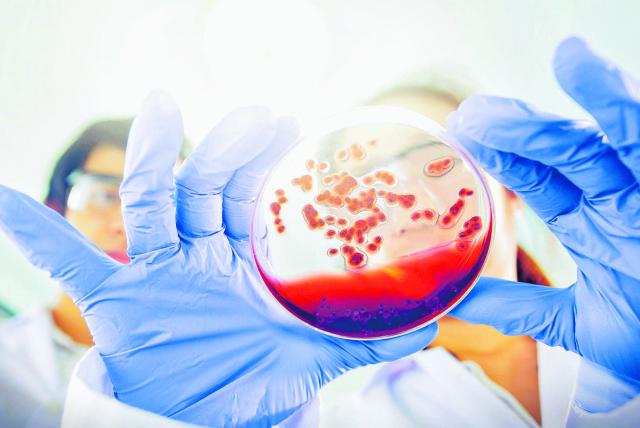

Según esas estadísticas divulgadas por ONUSIDA, 36,3 millones de personas fallecieron a causa de enfermedades asociadas con la enfermedad. Las cifras de contagio siguen preocupando.
Cerca de 80 millones de personas han resultado contagiadas con VIH-SIDA tras los primeros reportes registrados en 1981, de acuerdo con cifras oficiales. Es una lucha en la que se ha venido avanzando con la aparición de tratamientos y medicamentos para combatirlo y evitar su propagación. La ultima contribución contra la lucha es la aprobación de una inyección, la cual podría remplazar las píldoras diarias que debe de tomar las personas que padecen de esta enfermedad, por una dosis mensual de la inyección.
El próximo objetivo de Moderna con ARN mensajero: Vacuna contra cáncer, VIH y gripe.
La velocidad con la que Moderna, ideo sus vacunas, ha contribuido enormemente a la lucha para poner fin a la pandemia. Con una gran eficacia, un suministro constante y ningún riesgo de seguridad grave, las inyecciones de ARNm se han convertido en las vacunas de elección.
La farmacéutica Moderna empezará las pruebas de su vacuna contra el VIH el 19 de agosto del presente año y señalando que los ensayos deben terminar hacia la primavera de 2023. Tiene esperanzas en la eficacia y seguridad que ha mostrado la tecnología de ARN mensajero, la misma que esa compañía desarrolló para la que se aplica actualmente contra la covid-19.
Así lo publicó la revista Newsweek en un artículo en que se reveló que Moderna tiene dos candidatas a vacuna para el VIH: la mRNA-1644 y la mRNA-1644v2-Core, las cuales ya pasaron las pruebas iniciales de seguridad antes de ser usadas en humanos y ahora serán aplicadas a 56 participantes de entre 18 y 56 años que son negativos para el virus.

En mayo pasado, el CEO de Moderna, Stéphane Bancel, había advertido en una entrevista que la vacuna contra la covid-19 era sólo el comienzo, tras señalar que si el ARNm funcionaba, esto daría lugar a una nueva y gigantesca industria capaz de tratar casi todo, desde las enfermedades cardíacas hasta el cáncer y las afecciones genéticas poco frecuentes.
Pese a que desde hace varios años se han venido adelantando ensayos de vacunas contra el VIH/SIDA, es la primera vez que se utiliza esa tecnología (ARNm) que las haría más efectivas y seguras, y que les da la probabilidad de superar las etapas que otros fármacos no han podido pasar.
Uno de los desafíos más grandes que debe de superar la farmacéutica, es el hecho de que cuando hablamos de VIH existen millones de variantes debido a su rápido y prolongada ritmo de contagio. El VIH esta mutando tan rápidamente que difícil mostrarle al sistema inmunológico específicamente de que protegerse. Una vacuna exitosa necesitaría promover una amplia gama de anticuerpos que se adhieran a múltiples partes del virus, que causa el SIDA. Sin embargo, científicos confirman que en teoría si se pude desarrollar una vacuna «universal» que podría reconocer, tal vez no a todas sus variantes, pero si a una amplia gama.
Vale recalcar que esto es apenas el inicio de otro proceso, que en más de 40 años, no ha generado resultados satisfactorios, pero que con los avances alcanzados, buscando protección contra el covid-19, se espera que esta vez se logren algunos objetivos esperanzadores en la lucha contra el sida a nivel mundial. La buena noticia es que la adaptabilidad del ARNm también facilita probar muchas posibilidades. “Podemos escalar la cantidad de productos que tenemos en desarrollo a un ritmo que nunca antes se había hecho”, segun Bancel.

COMENTARIOS